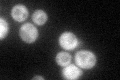
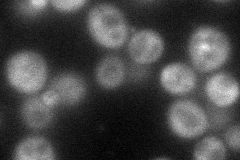
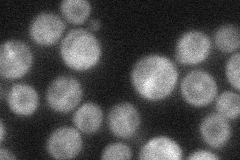

View description
Protein of unknown function involved in COPII vesicle formation; interacts with the Sec23p/Sec24p subcomplex; overexpression suppresses the temperature sensitivity of a myo2 mutant; has similarity to S. pombe Mpd2
Localization:
Intensity:
Fold change:
Significance:
-
C’ GFP library in SD
cytosol51.27 -
N' NOP1pr-GFP in SD
cytosol53.3872 -
N' TEF2pr-mCherry in SD

cytosol43.4604 -
N' NATIVEpr-GFP in SD
cytosol33.1461 -
N' TEF2pr-VC and Cyto-VN in SD

cytosol,punctate43.6748 -
C’ GFP library in SD+DTT

cytosol42.10.82No -
C’ GFP library in SD+H2O2

cytosol48.960.95No -
C’ GFP library in Starvation Media

cytosol25.930.5No -
C’ GFP library on the background of Pup2-DaMP

cytosol -
C’ GFP library on the background of CCT mutant

cytosol50.60030.98688No
